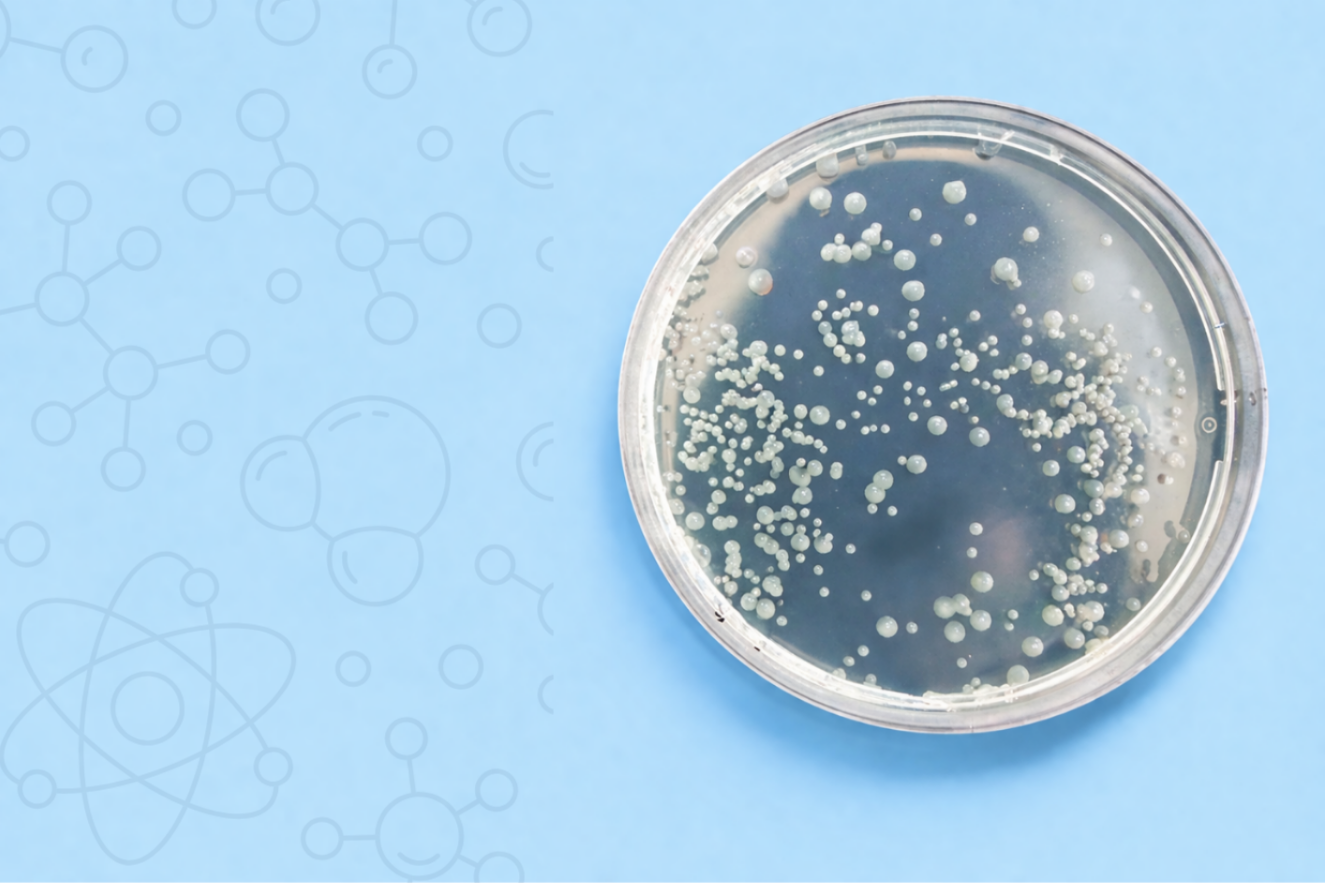
About the Use of PT2 and PT4 Biocidal Products in the Legionella Challenge

About the Use of PT2 and PT4 Biocidal Products in the Legionella Challenge
Legionella and Biocidal Products
Biocidal Products, that are manufactured or being on the market in Turkey, should have to be licensed according to Biocidal Products Regulation No:27449. The analyses of the Biocidal Products are performed in compliance with the Biocidal Products Laboratory Communique.
Microorganisms List Annex 17-18 of the Biocidal Products Laboratory Communique has been updated. L. pneumophila ATCC 33152 was added for the Biocidal products PT2: Public& Personal Areas; Equipment disinfectant and PT4: Food & Feed Areas; Equipment & Surface Disinfectant in order to effectively tackle Legionella.
